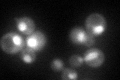
YIL035C
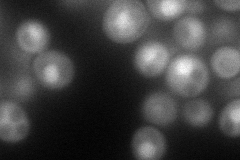
YIL035C
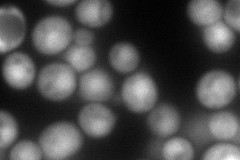
YIL035C
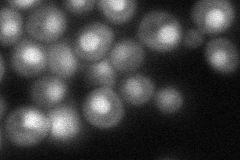
YIL035C
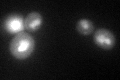
YIL035C

View description
Alpha catalytic subunit of casein kinase 2, a Ser/Thr protein kinase with roles in cell growth and proliferation; the holoenzyme also contains CKA2, CKB1 and CKB2, the many substrates include transcription factors and all RNA polymerases
Localization:
Intensity:
Fold change:
Significance:
-
C’ GFP library in SD
nucleus:cytosol73.2 -
N' NOP1pr-GFP in SD
cytosol,nucleus102.53 -
N' TEF2pr-mCherry in SD
nucleus165.48 -
N' NATIVEpr-GFP in SD
nucleus57.1174 -
N' TEF2pr-VC and Cyto-VN in SD

cytosol55.454 -
C’ GFP library in SD+DTT
nucleus.cytosol59.940.81No -
C’ GFP library in SD+H2O2

nucleus.cytosol79.411.08No -
C’ GFP library in Starvation Media

nucleus,cytosol87.081.18No -
C’ GFP library on the background of Pup2-DaMP

nucleus:cytosol -
C’ GFP library on the background of CCT mutant

nucleus:cytosol65.7210.897732No
